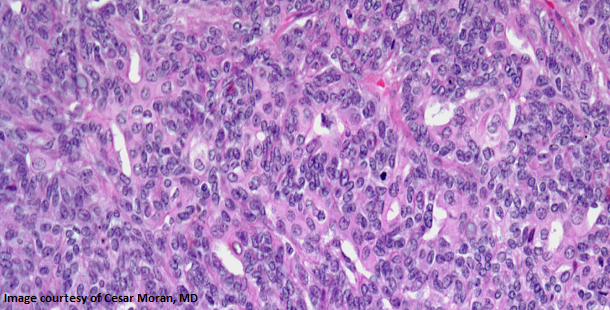
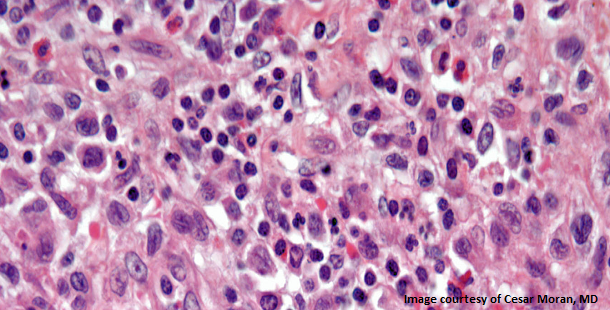

A 48-year-old woman presents with a lesion in the uterus. After the biopsy is performed, what is your diagnosis?
Polls

A 52-year-old man presents with a lesion on his eyelid, and a biopsy is performed. What is your diagnosis?

A 48-year-old man presents with a lesion on his forearm, and a biopsy is performed. What is your diagnosis?
A 37-year-old woman presents with a vulvar lesion. After further evaluation a biopsy is performed. What is your diagnosis?

A 60-year-old woman presents with vague abdominal pain in the right upper quadrant. An ultrasound reveals a gallbladder abnormality. Based on the images from the abdomen MRI, what is the diagnosis?

A 2-year-old child is found to have a pineal mass, and a biopsy is performed. What is your diagnosis?
.PNG?w=350&fit=crop&auto=format)
A 34-year-old woman presents with an increase in uterine bleeding. A biopsy is performed during a gynecologic examination. What is your diagnosis?

A lesion is found in the right breast of a 40-year-old woman, and a biopsy is performed. What is your diagnosis?

An 18-year-old man presents with a tumor in his humerus, and a biopsy is performed. What is your diagnosis?
.PNG?w=350&fit=crop&auto=format)
A 43-year-old woman presents with a gastric mass. After further assessment a biopsy is performed. What is your diagnosis?

A 32-year-old man presents with persistent diarrhea, and a colon biopsy is obtained. What is your diagnosis?

A 34-year-old woman presents with a lesion on the right side of her neck, and a biopsy is performed. What is your diagnosis?

A 27-year-old man presents with a lesion in the right scapular region, and a biopsy is performed. What is your diagnosis?
.PNG?w=350&fit=crop&auto=format)
A 38-year-old woman presents with a liver mass. After further evaluation a biopsy is performed. What is your diagnosis?

A 54-year-old man presents with abdominal pain, and a colon biopsy is obtained. What is your diagnosis?
.PNG?w=350&fit=crop&auto=format)
A 43-year-old man presents with a mass at the level of the filum terminale. After a biopsy is performed, what is your diagnosis?

A 43-year-old man presents with an anterior mediastinal mass. The mass is surgically resected and a biopsy is performed. What is your diagnosis?

A 19-year-old man is found to have a lesion in his nasopharynx, and a biopsy is performed. What is your diagnosis?
.PNG?w=350&fit=crop&auto=format)
A 47-year-old man presents with a lesion in the parotid gland. After further assessment, a biopsy is performed. What is your diagnosis?
.PNG?w=350&fit=crop&auto=format)
A 38-year-old woman presents with multiple pulmonary nodules. After further assessment a biopsy is performed. What is your diagnosis?

